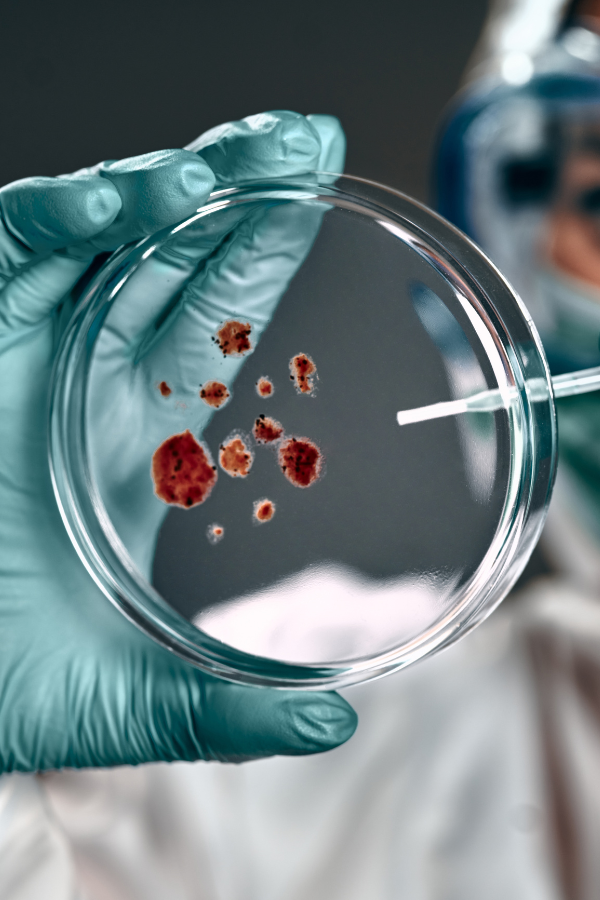

Meet ACTIVA,
your success partner
ACTIVA® International is a pioneer Egyptian specialty additives and biocides producer established in 2018. Our business works to apply our know-hows and expertise to create innovative tailored solutions that eliminate our customers’ challenges and satisfy their needs. Our aim is to make their production more efficient, help it meet higher quality standards and be completely immune to any destructive microorganisms. Our optimum target is to offer our customers the specialty additives they need while taking care of the three sustainability aspects of people, planet and economy.
Our line of biocide products and specialty additives are innovatively designed to maximize the performance and durability of our customer’s products. ACTIVA® offers a wide range of customized products that can help businesses preserve, optimize and rejuvenate their products and guarantee a healthy future for their businesses and for our next generations.
Industries

Coatings
Coatings

Detergents & Households
Detergents & Households

Cosmetics & personal care
Cosmetics & personal care

Pulp and paper
Pulp and paper

Water treatment
Water treatment

Construction
Construction

Agriculture
Agriculture

Plastics
Plastics

Textile
Textile

Fuel and Oil
Fuel and Oil
Services
Plant Hygiene
Laboratory Tests
TMS
A Special solution for every application
Our Success In Numbers
Some Interesting Readings
Follow our latest news, thoughts and industry updates. few minutes read, useful information gain.